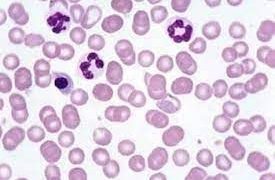

家畜中毒
家畜中毒 鉛 Lead Pb ~ 治療法
鉛中毒・治療法鉛の解毒薬は硫酸マグネシウム、芒硝、などの内用で、これは鉛を不溶性の硫化鉛として沈澱させる他、下剤として働くので急性症には特に適当です。鉛中毒時の特別な療法は石灰塩の応用です。前述の通り血中に入った鉛分は石灰と共に骨質内に沈着...
 家畜中毒
家畜中毒 家畜中毒
家畜中毒  家畜中毒
家畜中毒  家畜中毒
家畜中毒  家畜中毒
家畜中毒  家畜中毒
家畜中毒  家畜中毒
家畜中毒  家畜中毒
家畜中毒  家畜中毒
家畜中毒  家畜中毒
家畜中毒  消化と栄養
消化と栄養  ウシ(牛)の病気
ウシ(牛)の病気  S
S  アヒルの病気
アヒルの病気  ニワトリの病気
ニワトリの病気